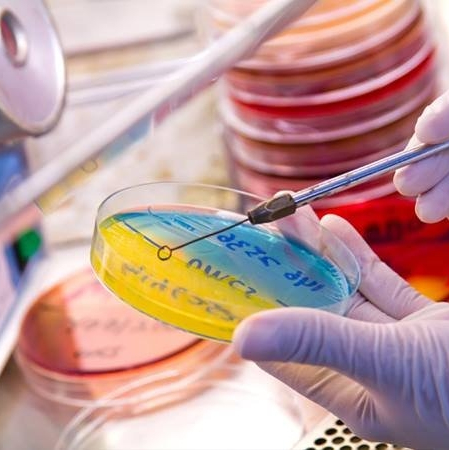

Conócenos
Somos parte de la red de laboratorios clínicos Grupo H, a través de ella nos preocupamos de ofrecer una amplia gama de exámenes Para el diagnóstico, control de patologías y seguimiento de terapias. respaldado con tecnología del más alto nivel, controles de calidad en Todas las áreas de nuestros procesos, programas de mejoramiento continuo y capacitaciones. Además para conocer los resultados, Laboratorio Clínico Valparaíso cuenta con entrega de exámenes vía web o bien, de manera tradicional retirando personalmente.
Política de Calidad Institucional
La principal tarea del Laboratorio CIínico Valparaíso, se centra en entregar servicios de laboratorio clínico de calidad, confiables, oportunos y precisos. El objetivo general de la institución es crear y fomentar una cultura que implique la revisión constante de los procesos y la instalación de un modelo De mejora continua de la calidad en todas sus unidades tanto clínicas como administrativas.
Para ello la Dirección del Laboratorio Clínico Ámsterdam se compromete a:
- Desarrollar un equipo de trabajo amplio, transversal y consensuado.
- Crear e implementar herramientas de gestión que permitan reducir la variabilidad y las ineficiencias existentes al producir o prestar servicios.
- Introducir mejoras que permitan prácticas más seguras, tanto para los pacientes como para los profesionales.
- Implementar una cultura de seguridad no punitiva.
- Fomentar el compromiso por parte de los colaboradores para mejorar los resultados, esto mediante un permanente apoyo formativo.
- Facilitar las herramientas y recursos necesarios para la implantación de sistemas de gestión de la calidad basados en normas y estándares reconocidos, tanto en servicios clínicos como en las áreas de gestión y apoyo.

Recepción de Muestras
Unidad encargada del correcto ingreso y preparación de las muestras, garantizando su calidad para luego distribuirlas en las diferentes unidades de procesamiento del laboratorio.

Hematología y Coagulación
En esta unidad se realiza el recuento de elementos celulares, estudio de su morfología y características, además de pruebas de coagulación, entre otros.

Bioquímica y Hormonas
Unidad destinada a analizar muestras de sangre y orina con autoanalizadores de alto rendimiento y calidad analítica permitiendo determinar las concentraciones de diferentes analitos presentes en las muestras.
Microbiología
Unidad cuya función principal es la búsqueda e identificación de agentes infecciosos como Bacterias y Hongos, realizar estudios de su sensibilidad a antibióticos aportando información indispensable para el diagnóstico y tratamiento de los pacientes.



